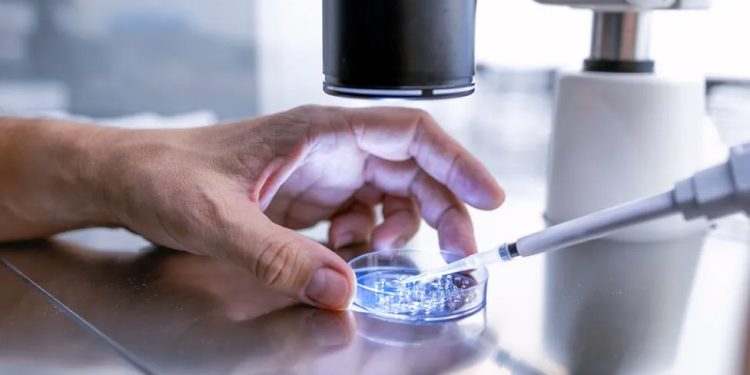
EUA: Hospital do Alabama interrompe a fertilização in vitro depois que o tribunal decide que embriões congelados são crianças

Uma decisão do Supremo Tribunal do Alabama de que os embriões congelados são considerados crianças e que uma pessoa pode ser responsabilizada por os destruir acidentalmente abriu uma nova frente na batalha dos EUA sobre a medicina reprodutiva.
O maior hospital do estado do sul dos EUA interrompeu os seus serviços de fertilização in vitro (FIV) na sequência da decisão, por receio de que pudesse expô-los a processos criminais.
O sistema de saúde da Universidade do Alabama em Birmingham disse que continuaria coletando óvulos dos ovários das mulheres. Mas disse que interromperia a próxima etapa do processo de fertilização in vitro, em que os óvulos são fertilizados com esperma antes de serem implantados no útero.
“Estamos tristes que isto terá impacto na tentativa dos nossos pacientes de ter um bebé através de fertilização in vitro”, disse o principal fornecedor médico estatal num comunicado.
“Mas devemos avaliar o potencial de que nossos pacientes e nossos médicos possam ser processados criminalmente ou enfrentar danos punitivos por seguirem o padrão de atendimento para tratamentos de fertilização in vitro”.
Especialistas médicos e grupos de defesa da reprodução alertaram que a decisão poderia ter consequências negativas para os tratamentos de fertilidade no Alabama e noutros locais.
Por que esse processo ocorreu e o que o tribunal decidiu?
O caso decorre de uma ação por homicídio culposo movida por três casais cujos embriões foram perdidos em uma clínica de fertilidade em 2020.
Um paciente entrou no local onde os embriões estavam armazenados, manuseou-os e deixou-os cair acidentalmente. Como resultado, os embriões foram destruídos.
Os casais procuraram processar o Centro de Medicina Reprodutiva e a Associação de Enfermaria Móvel sob a Lei de Morte Injusta de Menor do estado. Essa lei abrange fetos, mas não abrange especificamente embriões resultantes de fertilização in vitro.
Um tribunal de primeira instância decidiu que os embriões não se qualificavam como pessoa ou criança e que um processo por homicídio culposo não poderia avançar.
Mas na sua decisão, o Supremo Tribunal do Alabama apoiou os casais e decidiu que os embriões congelados eram considerados “crianças” .
Quais são as implicações para os pacientes de fertilidade do Alabama?
A decisão não proíbe nem restringe a fertilização in vitro e, de fato, os casais que instauraram o caso procuraram ativamente o procedimento.
Mas a decisão pode causar confusão sobre se alguns aspectos da fertilização in vitro são legais segundo a lei do Alabama, dizem os especialistas. Se um embrião for considerado uma pessoa, isso poderá levantar questões sobre como as clínicas podem usá-lo e armazená-lo.
Elisabeth Smith, diretora de política estadual do Centro de Direitos Reprodutivos, disse em comunicado: “Nem todos os embriões [de fertilização in vitro] são usados, nem podem ser. Promulgar legislação que conceda personalidade jurídica aos embriões poderia ter consequências desastrosas para o uso da fertilização in vitro – uma ciência na qual muitas pessoas confiam para construir as suas famílias”.
A Associação Médica do Estado do Alabama disse em um comunicado: “A importância desta decisão afeta todos os habitantes do Alabama e provavelmente levará a menos bebês – filhos, netos, sobrinhas, sobrinhos e primos – à medida que as opções de fertilidade se tornam limitadas para aqueles que desejam ter uma família”.
Como isso se relaciona com o debate sobre o aborto nos EUA?
Quando o Supremo Tribunal dos EUA derrubou o direito nacional ao aborto em 2022, abriu a porta para os estados criarem as suas próprias leis sobre a questão.
Desde a decisão, os estados controlados pelos Democratas expandiram o acesso, enquanto os estados controlados pelos Republicanos o restringiram.
O Alabama já proíbe totalmente o aborto, em todas as fases da gravidez.
A Casa Branca classificou a decisão do Alabama como “exatamente o tipo de caos que esperávamos quando a Suprema Corte derrubou Roe v Wade e abriu caminho para que os políticos ditassem algumas das decisões mais pessoais que as famílias podem tomar”.
Os oponentes do aborto também estão acompanhando de perto esta decisão. A questão de quando um embrião ou feto é legalmente considerado uma pessoa é um fator em muitas restrições estaduais ao aborto.
A Alliance Defending Freedom, um grupo jurídico cristão conservador, descreveu a decisão do Alabama como uma “tremenda vitória para a vida”.
“Não importa as circunstâncias, toda vida humana é valiosa desde o momento da concepção”, disse a porta-voz Denise Burke em comunicado. “Estamos gratos pelo Tribunal ter considerado corretamente que a lei do Alabama reconhece esta verdade fundamental.”
Outros ativistas antiaborto disseram que a fertilização in vitro não era uma questão ética tão clara aos seus olhos, em comparação com a interrupção de uma gravidez.
Eric Johnston, um advogado que ajudou a redigir a linguagem constitucional do Alabama sobre o aborto em 2018, disse: “Em geral, a comunidade pró vida diria que os óvulos fertilizados precisam de proteção”. Mas reconheceu que havia casais com opiniões antiaborto que recorreram à fertilização in vitro para ter filhos e disse que nunca os condenaria.
“É um dilema, e dilema é algo para o qual não se tem uma resposta satisfatória”, acrescentou.
Como esta decisão poderia afetar a política dos EUA?
O direito ao aborto tem sido uma questão vencedora para os Democratas desde que o Supremo Tribunal dos EUA derrubou o caso Roe v Wade, que garantia o direito constitucional ao aborto até ao ponto de viabilidade fetal, cerca de 23-25 semanas.
Na sequência da decisão do Alabama, os candidatos democratas poderiam concorrer com uma plataforma de proteção do acesso ao tratamento de fertilidade em todos os Estados Unidos.
Os políticos republicanos, por sua vez, muitas vezes ficam do lado dos conservadores religiosos que querem que o aborto seja proibido ou limitado nos EUA.
A candidata presidencial republicana Nikki Haley, a única candidata significativa restante na corrida contra Donald Trump pela indicação do partido, endossou a decisão da Suprema Corte do Alabama.
“Embriões para mim são bebês”, disse ela. “Quando você fala sobre um embrião, você está falando, para mim, que isso é vida e então eu vejo de onde isso vem quando eles falam sobre isso”.
Fonte: BBC News

Comente este post